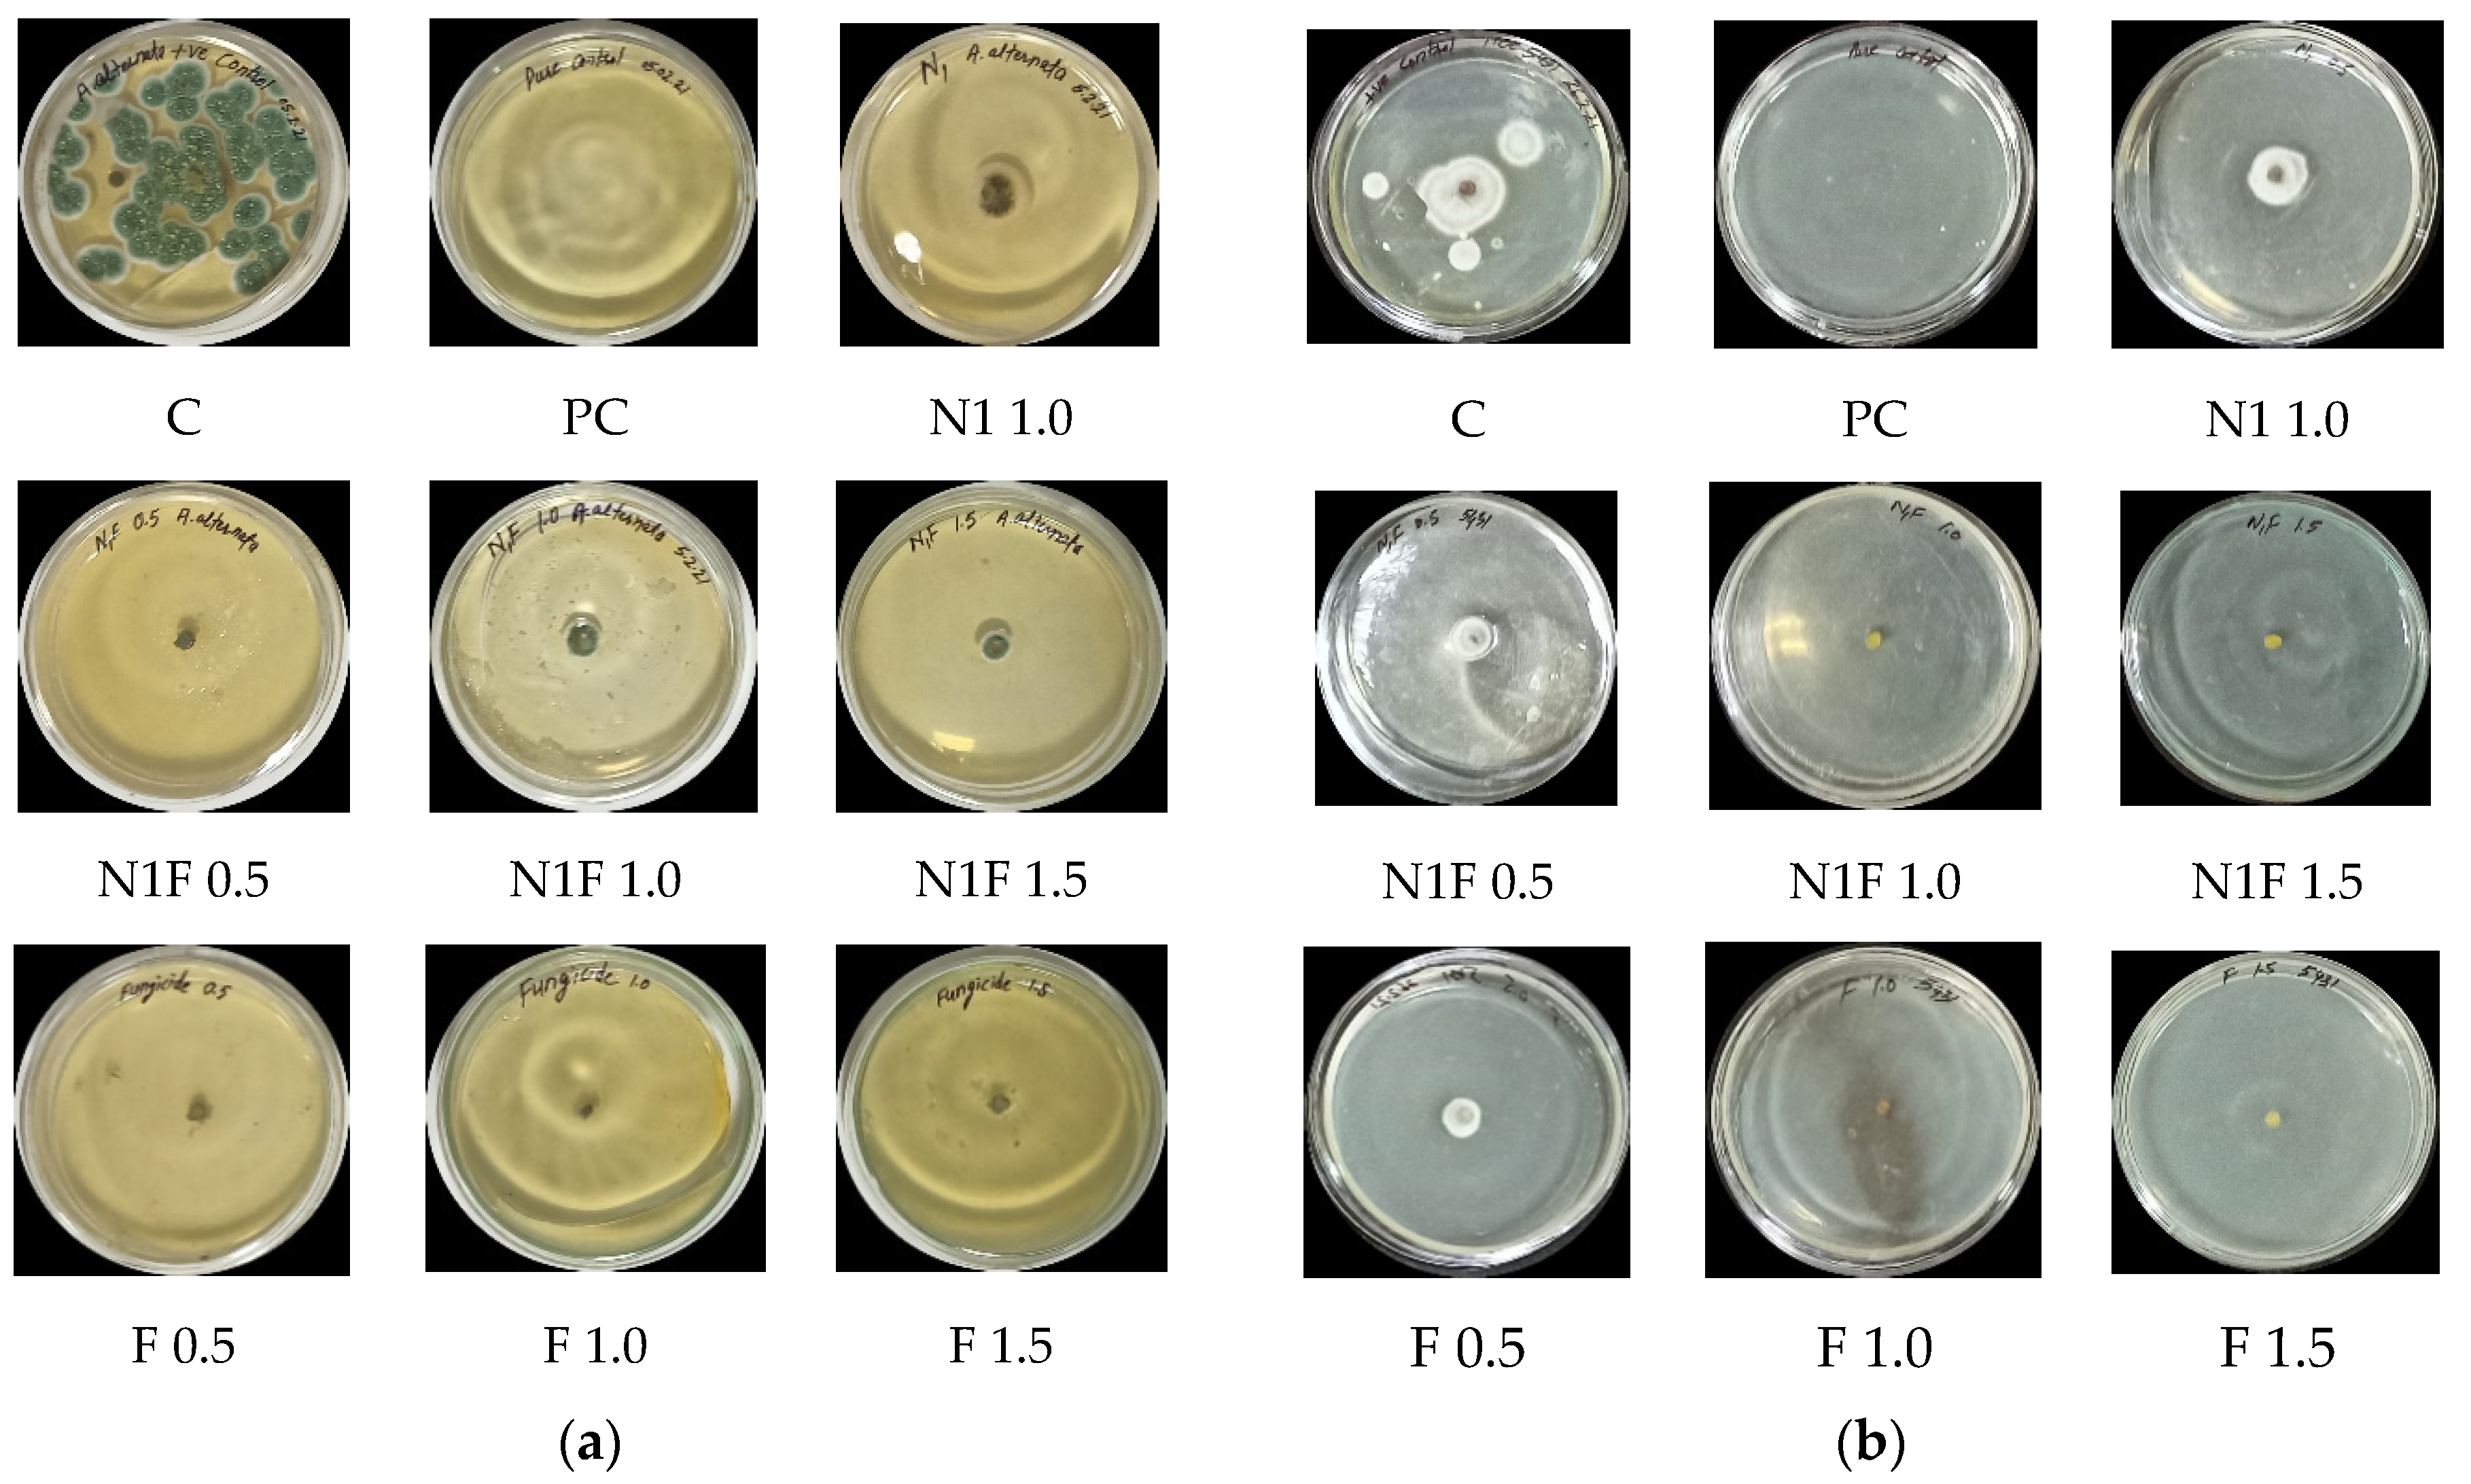
Jox 12 00023 g005

An Ecological Approach to Control Pathogens of Lycopersicon esculentum L. by Slow Release of Mancozeb from Biopolymeric Conjugated Nanoparticles
Abstract
:1. Introduction
2. Materials and Methods
2.1. Reagents and Materials Used
2.2. Synthesis of Blank and Mancozeb Loaded Chitosan–Gum Acacia Conjugated Nanoparticles
2.3. Optimization of Experimental Design
2.4. Characterization
2.4.1. Size, Polydispersity Index, and Zeta Potential
2.4.2. Fourier Transform Infrared (FTIR) Spectroscopy
2.4.3. Transmission Electron Microscopy (TEM)
2.4.4. Differential Scanning Calorimetry (DSC)
2.5. In Vitro Study
2.5.1. Encapsulation Efficiency (EE) and Loading Capacity (LC)
2.5.2. Slow-Release Profile of Conjugated CSGA NPs
2.5.3. Antimicrobial Activity
2.6. In Vivo Study
2.6.1. Bioefficacy in Pot House Conditions
2.6.2. Treatment of Seeds and Disease Detection
2.7. Statistical Treatment of Data
3. Results and Discussion
3.1. Nanoparticle Size Optimization, Stability, and Physicochemical Characterization
3.2. Storage Stability Determination
3.3. Ionic Group Interaction Study Using Fourier Transform Infrared Spectroscopy (FTIR)
3.4. Transmission Electron Microscopy (TEM)
3.5. Differential Scanning Calorimetry (DSC)
3.6. Encapsulation Efficiency and Loading Capacity
3.7. Controlled Release Behavior
3.8. In Vitro Antifungal Activity
3.9. In Vivo Antifungal Efficacy
3.10. Plant Growth Parameters Study
3.10.1. Effect of Treatment on Germination Percentage
3.10.2. Tomato Dry Mass per Plant
3.10.3. Root–Shoot Ratio of Plants
4. Conclusions
Author Contributions
Funding
Institutional Review Board Statement
Informed Consent Statement
Data Availability Statement
Acknowledgments
Conflicts of Interest
References
- Carvalho, F.P. Pesticides, environment and food safety. Food Energy Secur. 2017, 6, 48–60. [Google Scholar] [CrossRef]
- Stephenson, G.R. Pesticide use and world food production: Risks and benefits. In Environmental Fate and Effects of Pesticides; Coats, J.R., Yamamoto, H., Eds.; American Chemical Society: Washington, DC, USA, 2003; pp. 261–270. [Google Scholar]
- Tilman, D.; Cassman, K.G.; Matson, P.A.; Naylor, R.; Polasky, S. Agricultural sustainability and intensive production practices. Nature 2002, 418, 671–677. [Google Scholar] [CrossRef] [PubMed]
- Tudi, M.; Daniel, R.H.; Wang, L.; Lyu, J.; Sadler, R.; Connell, D.; Chu, C.; Phung, D.T. Agriculture development, pesticide application and its impact on the environment. Int. J. Environ. Res. Public Health 2021, 18, 1112. [Google Scholar] [CrossRef] [PubMed]
- Sharma, D.; Choudhury, P.P. Pesticide Use and Residue Management in Vegetables; Technical Bulletin No 74; ICAR-IIHR: Bangalore, India, 2018; 40p. [Google Scholar]
- Atuhaire, A.; Kaye, E.; Mutambuze, I.L.; Matthews, G.; Friedrich, T.; Jørs, E. Assessment of dithiocarbamate residues on tomatoes conventionally grown in Uganda and the effect of simple washing to reduce exposure risk to consumers. Environ. Health Insights 2017, 11, 1–8. [Google Scholar] [CrossRef] [Green Version]
- Raza, Z.A.; Khalil, S.; Ayub, A.; Banat, I.M. Recent developments in chitosan encapsulation of various active ingredients for multifunctional applications. Carbohydr. Res. 2020, 492, 108004. [Google Scholar] [CrossRef]
- Acemi, A.; Bayrak, B.; Çakır, M.; Demiryürek, E.; Gün, E.; El Gueddari, N.E.; Özen, F. Comparative analysis of the effects of chitosan and common plant growth regulators on in vitro propagation of Ipomoea purpurea (L.) Roth from nodal explants. Vitro Cell Dev. Biol.-Plants 2018, 54, 537–544. [Google Scholar] [CrossRef]
- Francesconi, S.; Steiner, B.; Buerstmayr, H.; Lemmens, M.; Sulyok, M.; Balestra, G.M. Chitosan hydrochloride decreases Fusarium graminearum growth and virulence and boosts growth, development and systemic acquired resistance in two durum wheat genotypes. Molecules 2020, 25, 4752. [Google Scholar] [CrossRef]
- Karthikeyan, C.; Tharmalingam, N.; Varaprasad, K.; Mylonakis, E.; Yallapu, M.M. Biocidal and biocompatible hybrid nanomaterials from biomolecule chitosan, alginate and ZnO. Carbohydr. Polym. 2021, 274, 118646. [Google Scholar] [CrossRef]
- Veiga, M.D.; Ruiz-Caro, R.; Martín-Illana, A.; Notario-Pérez, F.; Cazorla-Luna, R. Polymer gels in vaginal drug delivery systems. In Polymer Gels; Springer: Singapore, 2018; pp. 197–246. [Google Scholar]
- Bansal, P.; Kaur, P.; Duhan, J.S. Biogenesis of silver nanoparticles using Fusarium pallidoroseum and its potential against human pathogens. Ann. Biol. 2017, 33, 180–185. [Google Scholar]
- Bansal, P.; Kaur, P.; Kumar, A.; Duhan, J.S. Microwave assisted quick synthesis method of silver nanoparticles using citrus hybrid “Kinnow” and its potential against early blight of tomato. Res. Crop. 2017, 18, 650–655. [Google Scholar] [CrossRef]
- Mohamed, Y.M.A.; Elshahawy, I.E. Antifungal activity of photo-biosynthesized silver nanoparticles (AgNPs) from organic constituents in orange peel extract against phytopathogenic Macrophomina phaseolina. Eur. J. Plant Pathol. 2022, 162, 725–738. [Google Scholar] [CrossRef]
- Kaur, P.; Thakur, R.; Duhan, J.S.; Chaudhury, A. Management of wilt disease of chickpea in vivo by silver nanoparticles biosynthesized by rhizospheric microflora of chickpea (Cicer arietinum). J. Chem. Technol. Biotechnol. 2018, 93, 3233–3243. [Google Scholar] [CrossRef]
- Gupta, M.; Seema, K. Living Nano-factories: An eco-friendly approach towards medicine and environment. In Bio-Manufactured Nanomaterials; Springer: Cham, Switzerland, 2021; pp. 95–124. [Google Scholar]
- Paul, A.; Roychoudhury, A. Go green to protect plants: Repurposing the antimicrobial activity of biosynthesized silver nanoparticles to combat phytopathogens. Nanotechnol. Environ. Eng. 2021, 6, 10. [Google Scholar] [CrossRef]
- Al-Khattaf, F.S. Gold and silver nanoparticles: Green synthesis, microbes, mechanism, factors, plant disease management and environmental risks. Saudi J. Biol. Sci. 2021, 28, 3624–3631. [Google Scholar] [CrossRef] [PubMed]
- Prabha, A.S.; Thangakani, J.A.; Devi, N.R.; Dorothy, R.; Nguyen, T.A.; Kumaran, S.S.; Rajendran, S. Nanotechnology and sustainable agriculture. In Nanosensors for Smart Agriculture; Elsevier: Amsterdam, The Netherlands, 2022; pp. 25–39. [Google Scholar]
- Duhan, J.S.; Kumar, R.; Kumar, N.; Kaur, P.; Nehra, K.; Duhan, S. Nanotechnology: The new perspective in precision agriculture. Biotechnol. Rep. 2017, 15, 11–23. [Google Scholar] [CrossRef] [PubMed]
- Silva, A.O.; Cunha, R.; Hotza, D.; Machado, R. Chitosan as a matrix of nanocomposites: A review on nanostructures, processes, properties, and applications. Carbohydr. Polym. 2021, 272, 118472. [Google Scholar] [CrossRef] [PubMed]
- Agarwal, H.; Menon, S.; Venkat Kumar, S.; Rajeshkumar, S. Mechanistic study on antibacterial action of zinc oxide nanoparticles synthesized using green route. Chem. Biol. Interact. 2018, 286, 60–70. [Google Scholar] [CrossRef]
- Kumar, S.; Kumar, D.; Dilbaghi, N. Preparation, characterization, and bio-efficacy evaluation of controlled release carbendazim-loaded polymeric nanoparticles. Environ. Sci. Pollut. Res. 2017, 24, 926–937. [Google Scholar]
- Kaur, P.; Thakur, R.; Barnela, M.; Chopra, M.; Manuja, A.; Chaudhury, A. Synthesis, characterization, and in vitro evaluation of cytotoxicity, and antimicrobial activity of chitosan–metal nanocomposites. J. Chem. Technol. Biotechnol. 2015, 90, 867–873. [Google Scholar] [CrossRef]
- Kaur, P.; Duhan, J.S.; Thakur, R. Comparative pot studies of chitosan, and chitosan-metal nanocomposites as nano-agrochemicals against fusarium wilt of chickpea (Cicer arietinum L.). Biocatal. Agric. Biotechnol. 2018, 14, 466–471. [Google Scholar] [CrossRef]
- Maluin, F.N.; Hussein, M.Z.; Yusof, N.A.; Fakurazi, S.; Idris, A.S.; Hilmi, Z.; Jeffery Daim, L.D. Preparation of chitosan–hexaconazole nanoparticles as fungicide nanodelivery system for combating Ganoderma disease in oil palm. Molecules 2019, 24, 2498. [Google Scholar] [CrossRef] [PubMed] [Green Version]
- Kumar, S.; Chauhan, N.; Gopal, M.; Kumar, R.; Dilbaghi, N. Development, and evaluation of alginate-chitosan nanocapsules for controlled release of acetamiprid. Int. J. Biol. Macromol. 2015, 81, 631–637. [Google Scholar] [CrossRef] [PubMed]
- Zucker, R.M.; Ortenzio, J.; Degn, L.L.; Lerner, J.M.; Boyes, W.K. Biophysical comparison of four silver nanoparticles coatings using microscopy, hyperspectral imaging and flow cytometry. PLoS ONE 2019, 14, e0219078. [Google Scholar] [CrossRef] [PubMed] [Green Version]
- Kumar, R.; Najda, A.; Duhan, J.S.; Kumar, B.; Chawla, P.; Klepacka, J.; Malawski, S.; Sadh, P.K.; Poonia, A.K. Assessment of antifungal efficacy and release behavior of fungicide-loaded chitosan-carrageenan nanoparticles against phytopathogenic fungi. Polymers 2022, 14, 41. [Google Scholar] [CrossRef]
- Piran, F.; Khoshkhoo, Z.; Hosseini, S.E.; Azizi, M.H. Controlling the antioxidant activity of green tea extract through encapsulation in chitosan-citrate nanogel. J. Food Qual. 2020, 2020, 7935420. [Google Scholar] [CrossRef]
- Burhan, A.M.; Abdel-Hamid, S.M.; Soliman, M.E.; Sammour, O.A. Optimisation of the microencapsulation of lavender oil by spray drying. J. Microencapsul. 2019, 36, 250–266. [Google Scholar] [CrossRef]
- Kumar, R.; Duhan, J.S.; Manuja, A.; Kaur, P.; Kumar, B.; Sadh, P.K. Toxicity assessment and control of early blight and stem rot of Solanum tuberosum L. by mancozeb-loaded chitosan–gum acacia nanocomposites. J. Xenobiot. 2022, 12, 74–90. [Google Scholar] [CrossRef]
- Ali, H.; Kilic, G.; Vincent, K.; Motamedi, M.; Rytting, E. Nanomedicine for uterine leiomyoma therapy. Ther. Deliv. 2013, 4, 161–175. [Google Scholar] [CrossRef] [Green Version]
- Noor, F.; Zhang, H.; Korakianitis, T.; Wen, D. Oxidation and ignition of aluminum nanomaterials. J. Chem. Phys. 2013, 15, 20176–20188. [Google Scholar] [CrossRef]
- Hamadou, A.H.; Huang, W.C.; Xue, C.; Mao, X. Formulation of vitamin C encapsulation in marine phospholipids nanoliposomes: Characterization and stability evaluation during long term storage. LWT 2020, 127, 109439. [Google Scholar] [CrossRef]
- Kaur, I.; Agnihotri, S.; Goyal, D. Fabrication of chitosan–alginate nanospheres for controlled release of cartap hydrochloride. Nanotechnology 2021, 33, 025701. [Google Scholar] [CrossRef] [PubMed]
- Wang, Q.; Shen, M.; Li, W.; Li, W.; Zhang, F. Controlled-release of fluazinam from biodegradable PLGA-based microspheres. J. Environ. Res. Public Health Part B 2019, 54, 810–816. [Google Scholar] [CrossRef] [PubMed]
- Ashitha, A.; Mathew, J. Characteristics and types of slow/controlled release of pesticides. In Controlled Release of Pesticides for Sustainable Agriculture; Springer: Cham, Switzerland, 2020; pp. 141–153. [Google Scholar]
- Yusoff, S.N.M.; Kamari, A.; Ishak, S.; Halim, A.L.A. N-hexanoyl-O-glycol chitosan as a carrier agent for water-insoluble herbicide. J. Phys. Conf. Ser. 2018, 1097, 012053. [Google Scholar] [CrossRef]
- Kumar, S.; Bhanjana, G.; Sharma, A.; Dilbaghi, N.; Sidhu, M.C.; Kim, K.H. Development of nanoformulation approaches for the control of weeds. Sci. Total Environ. 2017, 586, 1272–1278. [Google Scholar] [CrossRef] [PubMed]
- Edge, M.; Seal, K.; Allen, N.S.; Turner, D.; Robinson, J. Enhanced Performance of Biocidal Additives in Paints and Coatings. In Industrial Biocides: Selection and Application; Karsa, D.R., Ashworth, D., Eds.; RSC: Cambridge, UK, 2002; pp. 84–94. [Google Scholar]
- Thirugnanasambandan, T. Advances of Engineered Nanofertilizers for Modern Agriculture. In Plant-Microbes-Engineered Nano-Particles (PM-ENPs) Nexus in Agro-Ecosystems; Springer: Cham, Switzerland, 2021; pp. 131–152. [Google Scholar] [CrossRef]
- De Oliveira, J.L.; Campos, E.V.; Camara, M.C.; Della Vechia, J.F.; de Matos, S.T.; de Andrade, D.J.; Goncalves, K.C.; Nascimento, J.D.; Polanczyk, R.A.; de Araujo, D.R.; et al. Hydrogels containing botanical repellents encapsulated in zein nanoparticles for crop protection. ACS Appl. Nano Mater. 2019, 3, 207–217. [Google Scholar] [CrossRef]
- Tong, Y.; Wu, Y.; Zhao, C.; Xu, Y.; Lu, J.; Xiang, S.; Zong, F.; Wu, X. Polymeric nanoparticles as a metolachlor carrier: Water-based formulation for hydrophobic pesticides and absorption by plants. J. Agric. Food Chem. 2017, 65, 7371–7378. [Google Scholar] [CrossRef]
- Maluin, F.N.; Hussein, M.Z.; Azah Yusof, N.; Fakurazi, S.; Idris, A.S.; Zainol Hilmi, N.H.; Jeffery Daim, L.D. Chitosan-based agronanofungicides as a sustainable alternative in the basal stem rot disease management. J. Agric. Food Chem. 2020, 68, 4305–4314. [Google Scholar] [CrossRef]
- Raliya, R.; Nair, R.; Chavalmane, S.; Wang, W.N.; Biswas, P. Mechanistic evaluation of translocation and physiological impact of titanium dioxide and zinc oxide nanoparticles on the tomato (Solanum lycopersicum L.) plant. Metallomics 2015, 7, 1584–1594. [Google Scholar] [CrossRef]
- Yasmeen, F.; Razzaq, A.; Iqbal, M.N.; Jhanzab, H.M. Effect of silver, copper and iron nanoparticles on wheat germination. Int. J. Biosci. 2015, 6, 112–117. [Google Scholar]
- Mehrian, S.K.; Heidari, R.; Rahmani, F.; Najafi, S. Effect of chemical synthesis silver nanoparticles on germination indices and seedlings growth in seven varieties of Lycopersicon esculentum Mill (tomato) plants. J. Clust. Sci. 2016, 27, 327–340. [Google Scholar] [CrossRef]
- Priester, J.H.; Ge, Y.; Mielke, R.E.; Horst, A.M.; Moritz, S.C.; Espinosa, K.; Holden, P.A. Soybean susceptibility to manufactured nanomaterials with evidence for food quality and soil fertility interruption. Proc. Natl. Acad. Sci. USA 2012, 109, E2451–E2456. [Google Scholar] [CrossRef] [PubMed] [Green Version]
- Zhao, L.; Sun, Y.; Hernandez-Viezcas, J.A.; Hong, J.; Majumdar, S.; Niu, G.; Gardea-Torresdey, J.L. Monitoring the environmental effects of CeO2 and ZnO nanoparticles through the life cycle of corn (Zea mays) plants and in situ μ-XRF mapping of nutrients in kernels. Environ. Sci. Technol. 2015, 49, 2921–2928. [Google Scholar] [CrossRef] [PubMed]

| CSGA NPs | Size (nm) | PDI | Zeta Potential (mV) |
|---|---|---|---|
| Freshly prepared nanoparticles | |||
| CSGA Blank | 322.2 ± 0.9 | 1.00 ± 0.1 | −23.2 ± 0.08 |
| CSGA-1.0 | 403.7 ± 0.7 | 0.789 ± 0.1 | −6.99 ± 0.5 |
| Storage stability of conjugated nanoparticles at 4 °C | |||
| CSGA Blank | 343.9 ± 0.5 | 0.255 ± 0.3 | 21.3 ± 0.4 |
| CSGA-1.0 | 413.1 ± 0.8 | 0.301 ± 0.7 | 25.0 ± 0.3 |
| Formulation | Encapsulation Efficiency (%) | Loading Capacity (%) |
|---|---|---|
| CSGA-0.5 | 15.95 ± 0.25 | 47.57 ± 0.39 |
| CSGA-1.0 | 36.62 ± 0.31 | 81.10 ± 0.18 |
| CSGA-1.5 | 57.13 ± 0.29 | 76.25 ± 0.26 |
| Fungi | Nanoformulation with Mancozeb (ppm) | CSGA NPs | NPs % Inhibition = dc − dt/dc × 100 | Mancozeb (ppm) | Mancozeb | Mancozeb % Inhibition = dc − dt/dc × 100 |
|---|---|---|---|---|---|---|
| Fungi Diameter (mm) | Fungi Diameter (mm) | |||||
| A. alternata (ITCC6343) | Blank NPs, N 1.0 | 18.5 ± 0.45 | 76.1 ± 0.22 b | - | - | |
| Loaded NPs, NF 0.5 | 11.5 ± 0.23 | 85.2 ± 0.61 b | F 0.5 | 12.0 ± 1.4 | 84.5 ± 1.4 b | |
| Loaded NPs, NF 1.0 | 15.5 ± 0.71 | 80.0 ± 0.42 b | F 1.0 | 11.5 ± 0.7 | 85.2 ± 0.7 b | |
| Loaded NPs, NF1.5 | 12.5 ± 0.96 | 83.9 ± 0.54 b | F 1.5 | 10.5 ± 0.7 | 86.5 ± 0.7 b | |
| S. lycopersici (ITCC5431) | Blank NPs, N 1.0 | 15.5 ± 0.7 | 53.0 ± 0.7 | - | - | |
| Loaded NPs, NF 0.5 | 12.5 ± 0.7 | 62.1 ± 0.7 | F 0.5 | 14.5 ± 0.7 | 56.1 ± 0.7 c | |
| Loaded NPs, NF 1.0 | 0 | 100 ± 0 a | F 1.0 | 0 | 100 ± 0 a | |
| Loaded NPs, NF 1.5 | 0 | 100 ± 0 a | F 1.5 | 0 | 100 ± 0 a |
| Treatment | A. alternata | S. lycopersici | ||
|---|---|---|---|---|
| % DS | % DCE | % DS | % DCE | |
| Pure control, C | 16.1 ± 1.4 | 00.0 ± 0.0 | 12.7 ± 1.5 | 00.0 ± 0.0 |
| Control + Pathogen, CP | 42.9 ± 3.3 | 00.0 ± 0.0 | 40.9 ± 0.8 | 00.0 ± 0.0 |
| Fungicide, F | 10.1 ± 1.9 | 76.5 ± 5.8 a | 10.2 ± 1.8 | 75.1 ± 1.8 a |
| Fungicide + Pathogen, FP | 14.6 ± 3.4 | 66.0 ± 3.5 b | 12.9 ± 2.3 | 68.5 ± 1.1 b |
| Blank NPs, N1 | 12.9 ± 0.5 | 69.9 ± 3.7 c | 16.0 ± 1.7 | 60.9 ± 1.9 c |
| Blank NPs + Pathogen, N1P | 15.6 ± 3.4 | 63.6 ± 1.5 | 15.0 ± 2.8 | 63.3 ± 4.6 |
| Loaded NPs, N1F | 10.0 ± 1.2 | 76.7 ± 3.4 a | 10.5 ± 1.2 | 77.3 ± 1.6 a |
| Loaded NPs + Pathogen, N1FP | 14.5 ± 1.4 | 66.2 ± 5.0 a | 12.0 ± 2.9 | 70.7 ± 1.6 a |
Publisher’s Note: MDPI stays neutral with regard to jurisdictional claims in published maps and institutional affiliations. |
© 2022 by the authors. Licensee MDPI, Basel, Switzerland. This article is an open access article distributed under the terms and conditions of the Creative Commons Attribution (CC BY) license (https://creativecommons.org/licenses/by/4.0/).
Share and Cite
Kumar, R.; Nain, V.; Duhan, J.S. An Ecological Approach to Control Pathogens of Lycopersicon esculentum L. by Slow Release of Mancozeb from Biopolymeric Conjugated Nanoparticles. J. Xenobiot. 2022, 12, 329-343. https://doi.org/10.3390/jox12040023
Kumar R, Nain V, Duhan JS. An Ecological Approach to Control Pathogens of Lycopersicon esculentum L. by Slow Release of Mancozeb from Biopolymeric Conjugated Nanoparticles. Journal of Xenobiotics. 2022; 12(4):329-343. https://doi.org/10.3390/jox12040023
Chicago/Turabian StyleKumar, Ravinder, Vikash Nain, and Joginder Singh Duhan. 2022. "An Ecological Approach to Control Pathogens of Lycopersicon esculentum L. by Slow Release of Mancozeb from Biopolymeric Conjugated Nanoparticles" Journal of Xenobiotics 12, no. 4: 329-343. https://doi.org/10.3390/jox12040023
APA StyleKumar, R., Nain, V., & Duhan, J. S. (2022). An Ecological Approach to Control Pathogens of Lycopersicon esculentum L. by Slow Release of Mancozeb from Biopolymeric Conjugated Nanoparticles. Journal of Xenobiotics, 12(4), 329-343. https://doi.org/10.3390/jox12040023









